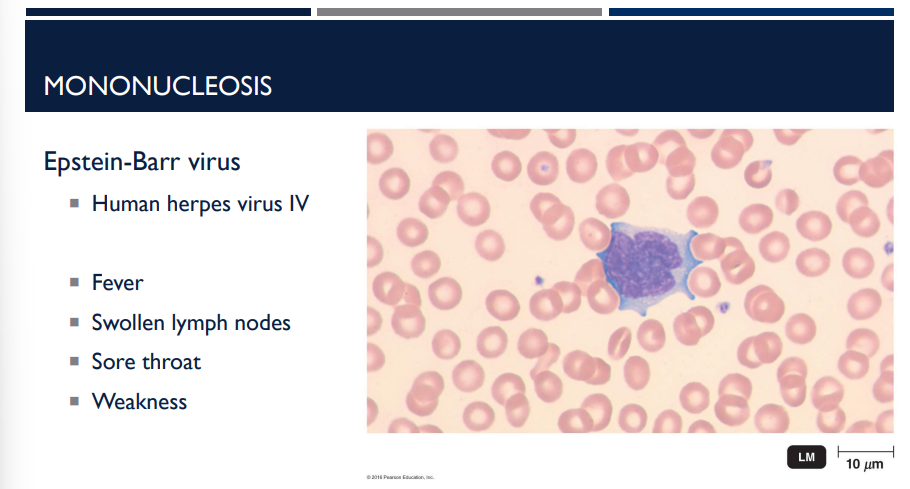
<p>Human herpes virus IV is also known as</p>
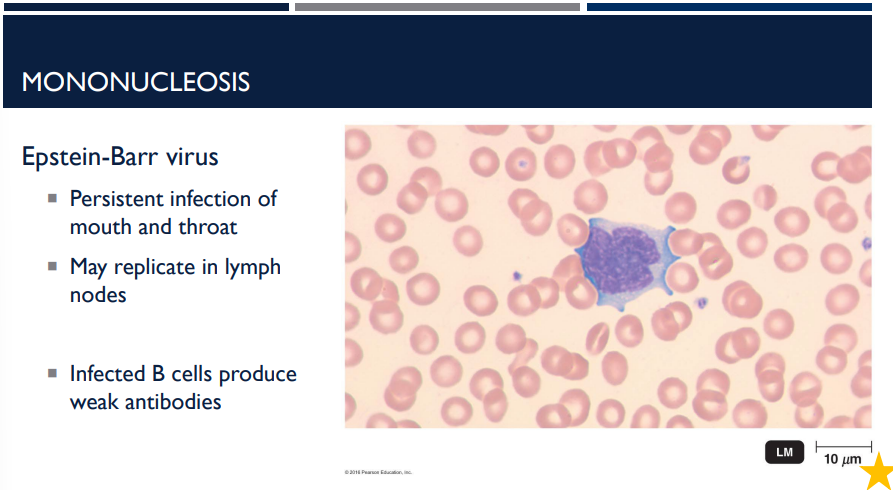
<p>Epstein-Barr virus is a persistent infection of the mouth and throat that may replicate in the ______ ____. Infected B cells produce weak ______.</p>
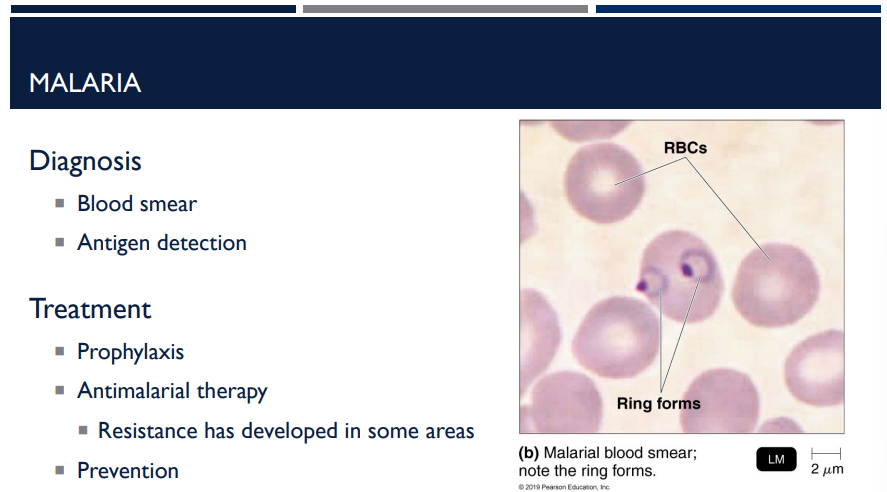
<p>How is malaria diagnosed?</p>
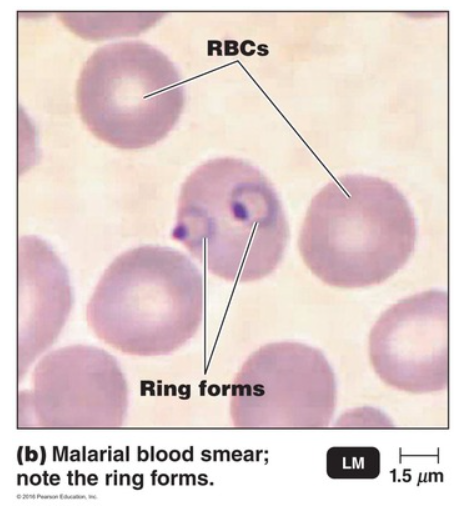
<p><strong>D</strong></p><p></p><p>A recurrent fever is common in cases of malaria. While this is not the only disease that can cause a recurrent fever, it is an important symptom for diagnosis of this disease.</p><p>—</p><p><strong>A</strong></p><p></p><p>A blood smear is commonly used for diagnosis of malaria. In cases of malaria, ring forms will be visible in red blood cells.</p><p>—</p><p><strong>E</strong></p><p></p><p><em>Plasmodium</em> species are carried by mosquitoes in the genus <em>Anopheles. </em>Mosquito control programs have helped to reduce cases of malaria in the USA.</p>

BIOL 251 Microbial Diseases of the Cardiovascular & Lymphatic Systems
1/93
There's no tags or description
Looks like no tags are added yet.
Name | Mastery | Learn | Test | Matching | Spaced |
|---|
No study sessions yet.
94 Terms

What is the lymphatic system’s job?
The lymphatic system is a network of vessels, nodes, and organs that helps maintain fluid balance and supports immunity.

Blood plasma leaks out of capillaries into tissues as _____ fluid.
This fluid carries nutrients and oxygen to cells.
interstitial

Interstitial fluid is collected by lymphatic vessels and filtered through lymph nodes. What do lymph nodes do and contain?
Lymph nodes are immune checkpoints where pathogens and debris are removed. They contain immune cells like:
Macrophages: Engulf and digest pathogens and cellular debris (phagocytosis)
B cells: Produce antibodies to neutralize specific pathogens (humoral immunity)
T cells: Mediate cell-mediated immunity, attacking infected or abnormal cells

What is the cardiovascular system’s job?
The cardiovascular system (heart, blood, and vessels) transports nutrients, gases, hormones, and waste throughout the body. It also plays a key role in defense against microbes.

Blood delivers substances to and from ______ ____.
body tissues.

Blood is normally sterile, meaning that bacteria are rarely ____ from blood. About what % of blood packs show bacterial growth?
cultured. Only about 0.1% of blood packs show bacterial growth.

How do microbes enter the blood?
Microbes enter during invasive procedures, injury, or from other tissues.

Where can bacterial DNA be found?
Bacterial DNA can be found in some blood cells and rarely in plasma

What are the defense mechanisms in blood?
White blood cells (leukocytes) patrol blood and tissues.
Antibodies and complement proteins help neutralize and destroy microbes.
Blood circulation ensures immune cells reach infection sites quickly.

What is septicemia? What are examples?
Acute illness associated with the presence and persistence of microbes in the blood
Bacteremia: Bacteremia is the presence of bacteria in the blood
Viremia: Viremia is the presence of viruses in the blood

What is sepsis?
Sepsis: Systemic inflammatory response syndrome caused by release of mediators of inflammation into the bloodstream

What is the difference between septicemia and sepsis?
Septicemia: Acute illness associated with the presence and persistence of microbes in the blood
Sepsis: Systemic inflammatory response syndrome caused by release of mediators of inflammation into the bloodstream

What is bacteremia and viremia (septicemia)?
Bacteremia: Bacteremia is the presence of bacteria in the blood
Viremia: Viremia is the presence of viruses in the blood

Sepsis is not defined by bacteria in the blood, it is defined by
your body’s extreme reaction to infection.

T/F: The bloodstream doesn’t have to be infected for someone to have sepsis.
T. You can get sepsis from any infection, such as:
Pneumonia
UTI
Skin infection
Abdominal infection
The infection may be in the lungs, kidneys, skin, etc. The problem is the body’s overreaction, not bacteria floating in blood.

T/F: The bloodstream must be infected for someone to have sepsis.
F.
You can get sepsis from any infection, such as:
Pneumonia
UTI
Skin infection
Abdominal infection
The infection may be in the lungs, kidneys, skin, etc. The problem is the body’s overreaction, not bacteria floating in blood.

T/F: During sepsis, Microbes may not be detectable in the blood.
T. Even though the inflammation is happening systemically, blood cultures can be negative in sepsis. This is because:
The bacteria might be localized (ex: lung or urinary tract)
They might not be continuously entering the bloodstream
The infection could be viral or fungal
The patient might already be on antibiotics
👉 You can have sepsis with negative blood cultures.

T/F: During sepsis, Microbes are detectable in the blood.
F. This is because:
The bacteria might be localized (ex: lung or urinary tract)
They might not be continuously entering the bloodstream
The infection could be viral or fungal
The patient might already be on antibiotics
👉 You can have sepsis with negative blood cultures.

The following symptoms are present in a patient:
Fever
Chills
Accelerated breathing
Increased heart rate
Lymphangitis
Septic shock (drop in blood pressure)
Organ failure
What are they likely going through?
Sepsis & Septic shock

What is septic shock?
A drop in blood pressure.
A drop in blood pressure is known as
septic shock

The most common cause of sepsis is (gram-positive/gram-negative) sepsis.
gram-positive sepsis
because Gram-positive bacteria commonly cause nosocomial (hospital-acquired) infections.
(More gpt context: Hospitals use many invasive devices → bacteria enter bloodstream
Frequent antibiotic use selects for resistant Gram-positives (MRSA, VRE)
High-risk patients (immunocompromised, surgical patients)

Staphylococci, streptococcoi, and enterococci are gram (positive/negative)
positive

What is the most common cause of sepsis and why? (hint: what do Staphylococci, streptococcoi, and enterococci have in common)?
gram-positive organisms because Gram-positive bacteria commonly cause nosocomial (hospital-acquired) infections.
(More gpt context: Hospitals use many invasive devices → bacteria enter bloodstream
Frequent antibiotic use selects for resistant Gram-positives (MRSA, VRE)
High-risk patients (immunocompromised, surgical patients)

enterococci is a gram-positive bacteria that is among the most common cause of sepsis. describe its characteristics that make it so deadly and dangerous.
It is resistant to penicillin and other antibiotics.

A patient is shown to have Enterococcus faecium in their system. What makes this particular bacteria so dangerous?
enterococci is a gram-positive bacterium that is resistant to penicillin and other antibiotics.

What bacterium is puerperal sepsis caused by?
Streptococcus pyogenes

What is puerperal sepsis?
A severe infection of the female reproductive tract that occurs after childbirth. It can progress to sepsis or septic shock if untreated.

The main cause of puerperal sepsis is Streptococcus pyogenes. This organism is highly virulent and invasive. What is another key characteristic it has?
S. pyogenes is a beta-hemolytic strep. β-hemolytic strains are the ones associated with serious, rapid-spreading infections.

A patient presents with a severe infection of the female reproductive tract that occurs after childbirth. It can progress to sepsis or septic shock if untreated. What is the type of sepsis that is occurring/would occur?
Puerperal sepsis

(LC) Why would treatment with antibiotics worsen the symptoms of Gram-negative sepsis?
The organisms are resistant to the antibiotics
Treatment with antibiotics causes side effects
Bacterial endotoxins are released when the cells die
The antibiotics can not reach the site of infection
C
Gram negative bacteria contain endotoxins as part of their cell wall. Antibiotics can cause lysis of the bacterial cells. This, in turn, releases more endotoxins, worsening the symptoms of the infection.


Gram-negative sepsis is very common and very deadly. There are over 750,000 cases/year and 225,000 deaths/year. Why is it so dangerous?
It can release bacterial endotoxins.
Symptoms are caused by the host immune response, which is “unhelpfully exuberant” (The body’s immune system overreacts to LPS. Cytokine storm → inflammation everywhere → blood vessels leak → low blood pressure → organ failure.)
Gram-negative bacteria have lipopolysaccharide (LPS) in their outer membrane.
When bacteria multiply or die → LPS is released.
LPS = endotoxin → triggers a massive immune response.

T/F: With gram negative sepsis, the immune response, not the bacteria themselves, causes most of the damage.
T, Symptoms are caused by the host immune response, which is “unhelpfully exuberant” (The body’s immune system overreacts to LPS. Cytokine storm → inflammation everywhere → blood vessels leak → low blood pressure → organ failure.)

A patient may look OK at first, but then decline within hours in what type of sepsis?
Gram-negative sepsis. Early symptoms are mild, but disease progresses rapidly. Because early symptoms are mild, many patients do not seek immediate treatment and this delay increases the risk of septic shock.

A patient may look OK at first, but then decline within hours with gram-negative sepsis. Early symptoms are mild, but the disease progresses rapidly. Why does this increase the risk of septic shock?
Because early symptoms are mild, many patients do not seek immediate treatment and this delay increases the risk of septic shock.

What is endocarditis?
inflammation of the endocardium, the inner lining of the heart, usually involving the heart valves.

What are the two major forms of endocarditis? (just name, don’t describe)
Subacute bacterial endocarditis
Acute bacterial endocarditis

The two major forms of endocarditis is Subacute bacterial endocarditis and Acute bacterial endocarditis. Describe subacute bacterial endocarditis, especially the bacteria it is caused by.
Fever
Weakness
Heart murmur
Alpha-hemolytic streptococci

The two major forms of endocarditis is Subacute bacterial endocarditis and Acute bacterial endocarditis. Describe acute bacterial endocarditis, especially the bacteria it is caused by.
Rapid progression
Fatal in days/weeks
Staphylococcus aureus

Which form of endocarditis progresses rapidly and is fatal in days/weeks? (Hint: Caused by Staphyloccus aureus)
Acute bacterial endocarditis

What bacterium causes anthrax?
Bacillus anthracis

Describe the characteristics of the bacterium that causes anthrax.
Bacillus anthracis
Gram-positive
Aerobic
Edospore-forming
Capsule of amino acids
Does not stimulate an immune response. The immune system normally recognizes sugars on capsules.
But the anthrax capsule is made of amino acids, which look “self-like” to the immune system.

Describe the proliferation of Bacillus anthracis in anthrax.
Endospores enter body and germinate in macrophages
Vegetative cells multiply in macrophages
Macrophage dies
Bacteria are released

Bacillus anthracis, the bacterium causing anthrax, has a capsule of amino acids that do not stimulate an immune system response. Why?
The immune system normally recognizes sugars on capsules.
But the anthrax capsule is made of amino acids, which look “self-like” to the immune system.
The capsule is poorly immunogenic → it doesn’t trigger antibodies → makes the bacteria harder to detect and phagocytose.

Anthrax produces two major exotoxins — both are required for full virulence. Proliferation in blood leads to production of large amounts of toxin. What are they & describe them?
Edema toxin: Swelling; interferes with phagocytosis
Lethal toxin: kills macrophages

Which exotoxin involved with anthrax kill macrophages?
Lethal toxin

Which exotoxin involved with anthrax causes swelling and interferes with phagocytosis?
The edema toxin

There are many different types of anthrax, including cutaneous anthrax, gastrointestinal anthrax, and inhalation (pulmonary) anthrax. Describe cutaneous anthrax.
Endospores enter through minor skin lesion
Mild fever + malaise
Mortality ~20% if untreated (1% if treated)

There are many different types of anthrax, including cutaneous anthrax, gastrointestinal anthrax, and inhalation (pulmonary) anthrax. Describe gastrointestinal anthrax.
Consumption of food contaminated with endospores. Mortality > 50%

There are many different types of anthrax, including cutaneous anthrax, gastrointestinal anthrax, and inhalation (pulmonary) anthrax. Describe inhalation (pulmonary) anthrax.
Endospores are inhaled
High probability of organism entering bloodstream
Early symptoms: mild fever, cough, chest pain
Antibiotic can stop illness here
Progresses to septic shock in 2-3 days
Death within 24-36 hours
Mortality rate near 100%

Inhalation anthrax is also known as
pulmonary anthrax.

There are many different types of anthrax, including cutaneous anthrax, gastrointestinal anthrax, and inhalation (pulmonary) anthrax. Which one is the most fatal, with a mortality rate near 100%, death within 24-36 hours, and the progression of septic shock in 2-3 days?
inhalation (pulmonary) anthrax.

In the context of gangrene, what is ischemia?
Ischemia = interruption of blood supply
When blood flow is cut off (due to injury, blockage, pressure, or infection), the tissues no longer receive:
Oxygen
Nutrients
Immune cells
👉 Without oxygen, tissues quickly begin to die.

In the context of gangrene, what is necrosis?
Necrosis = tissue death
Ischemia leads to cell death because cells can’t survive without oxygen.
Necrotic tissue becomes:
Dark
Cold
Dead
Often foul-smelling if infection is present

What is gangrene?
Gangrene = loss or death of soft tissue due to ischemia.
It is the end result of prolonged ischemia + necrosis.
Tissue basically “dies and rots.”
Often seen in:
Diabetes
Frostbite
Severe wounds
Atherosclerosis
Crushing injuries

What is gas gangrene?
Gas gangrene, or clostridial myonecrosis, is a rare and life-threatening infection of the body's tissues that causes tissue death and produces gas.

In the pathogenesis of gas gangrene, there is a lack of oxygen, which causes necrosis & gangrene, which provides an environment that is good for the growth of
anaerobic bacteria

In the pathogensis of gas gangrene, the wound first interrupts the blood supply which causes
ischemia

Describe the pathogenesis of gas gangrene.
Wound interrupts blood supply → ischemia
Lack of oxygen → necrosis & gangrene
Provides environment for growth of anaerobic bacteria
Bacteria ferment sugars to produce gas → tissue swelling
Bacterial toxins damage tissue
Toxins enter bloodstream → systemic illness

What is the bacterium that causes gas gangrene? What are its characteristics?
Clostridium perfringens.
Gram-positive rod
Anaerobic → grows only when oxygen is low or absent
Endospore-forming
Major cause of gas gangrene (clostridial myonecrosis)

What are the 3 treatments of gas gangrene?
Debridement – removal of necrotic tissue
Amputation
Hyperbaric chamber (100% O2)

What is the bacterium that causes plague? What are its characteristics?
Yersina pestis
Gram-negative
Rod-shaped
Transmitted by rat fleas
Flea bites human
Bacteria enter bloodstream
Bacteria multiply in blood and lymph
Lymph nodes swell and fever develops

Yersina pestis, the bacterium that causes plague, is transmitted by
rat fleas

There are many different types of plague, including bubonic plague, septicemic plague, and pneumonic plague. Describe bubonic plague.
Bubonic plague – swelling in lymph nodes (buboes)
Mortality rate: 50-75% if untreated

There are many different types of plague, including bubonic plague, septicemic plague, and pneumonic plague. Describe septicemic plague.
Septicemic plague – bacteria in blood stream cause bleeding into skin and septic shock
Mortality rate: almost 100% if untreated

There are many different types of plague, including bubonic plague, septicemic plague, and pneumonic plague. Describe pneumonic plague.
Pneumonic plague - Bloodstream carries bacteria to the lungs
Mortality rate: almost 100% if untreated
Difficult to control if not recognized early (12-15 hours after fever develops)
Can spread through respiratory droplets

There are many different types of plague, including bubonic plague, septicemic plague, and pneumonic plague. Which one can spread through respiratory droplets?
Pneumonic plague

There are many different types of plague, including bubonic plague, septicemic plague, and pneumonic plague. Which two has a mortality rate of almost 100% if left untreated?
Septicemic plague and pneumonic plague

There are many different types of plague, including bubonic plague, septicemic plague, and pneumonic plague. Which one has a mortality rate of 50-75% if left untreated?
Bubonic plague

What is the bacterium that causes lyme disease? What are its characteristics?
Borrelia burgdorferi
Spirochete
Microaerophilic
Spread by ticks

How is Borrelia burgdorferi, the bacteria causing lyme disease, spread?
Spread by ticks

How is Lyme disease diagnosed?
fluorescent antibody test

What virus causes mononucleosis?
Epstein-Barr virus
Human herpes virus IV

mononucleosis is caused by what virus?
Epstein-barr virus, also known as Human herpes virus IV

lyme disease is caused by what bacteria?
borrelia burgdorferi

Epstein-Barr virus is also known as
Human herpes virus IV
Human herpes virus IV is also known as
the Epstein-Barr virus.
Epstein-Barr virus is a persistent infection of the mouth and throat that may replicate in the ______ ____. Infected B cells produce weak ______.
lymph nodes; antibodies

What is Burkitt’s lymphoma and the virus it is caused by? In what types of patients does it occur in?
Tumor of the jaw, caused by Epstein-Barr virus. Often occurs in patients with compromised immune systems, like those with Malaria and AIDS.

What are emerging viral hemorrhagic fevers and what symptoms do they all have in common?
Viral hemorrhagic fevers (VHFs) are severe diseases caused by certain RNA viruses.
What they all have in common is that they damage blood vessels and disrupt normal blood clotting, which leads to high fever and excessive bleeding.
leaky vessels + inability to clot = hemorrhage.

What is the most signficant and major emerging hemorrhagic virus?
Ebolavirus

The major Ebola outbreak occurred in the Democratic Republic of Congo (DRC between 2018 and 2020. How was it taken care of?
Vaccination of high risk individuals
Transmission was reduced by security measures

What causes malaria? How is it spread?
Malaria is caused by Plasmodium, a protozoan parasite (not bacteria or virus). It is spread by mosquitos.

T/F: Plasmodium, the parasite causing malaria, is a virus.
F, Plasmodium is a protozoan parasite (not bacteria or virus).

T/F: Plasmodium, the parasite causing malaria, is a bacteria.
F, Plasmodium is a protozoan parasite (not bacteria or virus).

T/F: Plasmodium, the parasite causing malaria, is a protozoan.
T

Symptoms recur every 2-3 days in what disease?
Malaria
Here’s why:
Inside the body, Plasmodium multiplies in two places:
Liver cells
Red blood cells (RBCs)
The parasite stage that breaks out of RBCs is called merozoites.
This cycle happens roughly every ~48 hours, which is why symptoms come in waves.

Which disease is spread by mosquitoes?
Malaria

How does the protozoan parasite, Plasmodium, grow?
Inside the body, Plasmodium multiplies in two places:
Liver cells
Red blood cells (RBCs)
The parasite stage that breaks out of RBCs is called merozoites.
This cycle happens roughly every ~48 hours, which is why symptoms come in waves.

What protozoan parasite is the most dangerous malaria with a 50% morality rate untreated?
Plasmodium falciparum

With plasmodium falciparum, a protozoan parasite causing the most dangerous malaria, what does it do that is so destructive?
Clogged capillaries lead to loss of blood supply to tissues → kidney and liver damage
Destruction of RBCs → anemia
How is malaria diagnosed?
Through a blood smear and antigen detection (where in a blood smear, a ring forms).

How is malaria treated?
Prophylaxis
Antimalarial therapy
Resistance has developed in some areas
Prevention
(LC) A patient presents with a fever, sweats, muscle aches, and a pounding headache. His symptoms started six days ago, but he started to feel better the next day. Two days later his symptoms returned and then improved. This is now the third time these symptoms have appeared in the last week.
You are concerned about the recurrent fever in your patient. What disease might cause this symptom?
Cutaneous anthrax
Gas gangrene
Lyme disease
Malaria
Plague
Septicemia
Mononucleosis
Viral hemorrhagic fever
Part 2:
What test should be performed to confirm the cause of your patient’s illness?
Blood smear
Culture a blood sample for bacterial pathogens
Culture a sputum sample for bacterial pathogens
Direct fluorescent antibody test
Part 3:
The patient is a caterer and worked at an event at a nearby country club. Seven other patients have been identified and all of them worked or visited the country club. What vector organism were these patients most likely exposed to?
Sand flies
Ticks
Grazing livestock or unpasteurized dairy products
Sliver-haired bats
Mosquitoes
D
A recurrent fever is common in cases of malaria. While this is not the only disease that can cause a recurrent fever, it is an important symptom for diagnosis of this disease.
—
A
A blood smear is commonly used for diagnosis of malaria. In cases of malaria, ring forms will be visible in red blood cells.
—
E
Plasmodium species are carried by mosquitoes in the genus Anopheles. Mosquito control programs have helped to reduce cases of malaria in the USA.